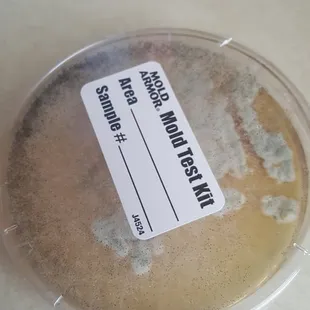
home mold test done, this is what grew in 48 hrs
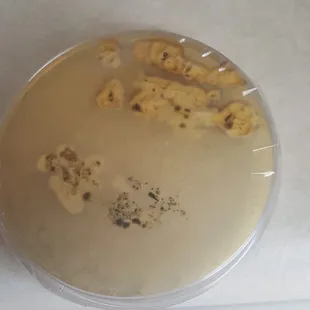
underside of mold test, it's disgusting to think anyone that came into my apartment *C07* was breathing this in.

Fully-Equipped Upscale Kitchen Corpus Christi, TX

Diningroom black mold

Hallway black mold

Under the kitchen sink in a four winds "move-in ready" unit.

Two-bedroom apartments Corpus Christi, TX

Swimming Pool Corpus Christi, TX

Open-Concept Floor Plans Corpus Christi, TX

One-bedroom apartments Corpus Christi, TX

One-bedroom apartments Corpus Christi, TX

Apartment Apartments near Corpus Christi, TX

Apartment Real apartments Corpus Christi, TXstate

Apartments near Corpus Christi, TX

Apartments for Clubhouse in Apartments Corpus Christi, TXrent

Behind the stove and fridge

Four Winds Clubhouse

Roaches out of outlets

and this was a good day, it's usually much worse

Roach eggs under the stove after cleaning 2 months earlier
home mold test done, this is what grew in 48 hrs
underside of mold test, it's disgusting to think anyone that came into my apartment *C07* was breathing this in.

they replaced my stove after over a month of it not working only to replace it with this filthy one! (pic 1 of stove)

old dishwasher was left outside the downstairs apt. door and was left there for over a week.

mold scraped from the AC unit!


Tiffany W.
Mar 6, 2022
I would describe the facility (four winds apartment homes - corpus christi by sandalwood property management company) and practices of said facility as delapidated, decrepit, deplorable, damning, disappointing, disingenuous, disheartening, despicable, and down right dangerous. We are immediately leaving this facility due to these permitted substandard living conditions. I mean...come on! No locks on a first floor window, mold that even made the fire marshal start coughing, bedrooms with no associated smoke detectors, no lights outside or near by your door, still infested when they rent it, holes into the dry wall, a thermostat that didnt work, creepy male neighbors staring into your windows that dont lock. I could go on and on but every negative thing you end up reading is consistent and true. Btw they only have one hot water heater for the WHOLE property so if youre in building A it will burn your skin off, if youre in building z you will probably not ever have a hot showed your whole time here. Not kidding about the burnt skin part. Their water burnt a child and they almost got sued. Oh yea how could i forget... Thats even if you have water. They shut it off almost every week, and according to the residents have been doing that for at least the last five years consistently. I wish they ran a business they could be proud of, but instead they are taking advantage of the disparity of impoverished families. How do they sleep at night knowing they are subjecting people to these kinds of living standards?? We are lucky enough not to face disparity such as this thus we are taking our business to a 4.5 star, very well maintained facility, pretty close by that really doesnt cost an arm and a leg more... Something to keep in mind.
Read More
Kat T.
Jan 18, 2020
Worse place I have lived so far. The whole apartment complex looks like a mess with all the leaves of the trees all over the place , the Pools are only clean on Monday and it is close on that day so when you go the next day is full of leaves and the water turns green super fast too. The whole place is infesten with roaches, I have try so many things but nothings webs to work because they keep coming back. The manager never has time to sit and talk to you about the issues you might have even if it is a safety thing, the other ladies try but there isn't much they can do anyways. Leaving the place before my contract is even over but will continue to pay, I just can't live in a place like this any longer.
Read More
Cassie L.
Dec 26, 2014
DO NOT MOVE here it's an awful place. I lived here for 2 years at different apartments and it's been awful! First apartment I lived in was infested with ants I called the office and they said they sprayed and tried to blame me for not cleaning. Then I moved to a two bedroom apartment and they had roach problems I've told them over and over that they need to spray again. They said they spray every other month my sister does online classes and never seen them walk in and spray when they do its two corners in kitchen and in bathroom which never helps! When we called to complain they once again did nothing to help. We have roaches there eggs in the clothes in food in the stove in wall outlets ac units. We've complained about stuff being broken and still havnt fixed it. I've talked to neighbors they all seem to have the same problems. The lady Blanca in the office can be very rude at times.
Read More
Franklin B.
Dec 4, 2017
I have been living at Four Winds for the past 5 years, I have nothing but good things to say about this place. First I live in a two bedroom apartment for only $850 a month, that is a steal for Corpus Christi, TX! The staff in the front office are always friendly and nice and have always treated myself and other residents with respect and kindness. Every-time I go to the office the staff always greet me with a smile and have helped with whatever issues I may have or just chit chat with me while I wait for one of my packages to arrive (many of the bigger packages arrive directly to the front office, this I like as it prevents anyone from taking packages or delivery people from placing them at the wrong apartment). I have had 0 bug issues in my place as they do regular pest control and whenever I had maintenance issues (like after the hurricane) they have always responded promptly and took care of the ceiling and the small amount of damage that occured. There are also quite a few trash bins all over the property so it is never a far walk to take out the garbage. They are also now pet friendly, so that is also a plus for pet owners and non-pet owners as the residents generally clean up after themselves and the groundskeepers are always cleaning the property. I am also happy that they started doing renovations around the buildings and have fixed many of the roofs on the property and giving the place a new paint job. A++ place to live and is very close to HEB, schools, and restaurants.
Read More
Eddie B.
May 13, 2015
Do not even think about living here!!!!!! The staff is sooooo sweet-until you sign the lease, and then they are the rudest people ever!!!!!! The first day we moved in the sewage overflows. Feces all over the sidewalk. This happened all the time. They can't explain where your 200 dollar deposit goes, if you leave a nail hole in the wall, they charge you. If you leave a stain on the wall they charge you, even though they have to repaint anyway. Unless you are willing to have this apartment make ready when you move out, they will try to screw you!!!! I would NEVER EVER refer anyone there. Worst place I have ever ever lived. And even though the air conditioner wouldn't cool lower than 80 degrees- it was working fine!
Read More
Bill C.
Feb 14, 2025
I have lived in Four Winds Apartment Complex for two years. We have lived in two units moving to a larger unit a few months ago. Unit is clean and everything fully functional.We have no complaints. When there is a maintenance issue it is addressed. The maintenance crew and front office friendly and treat us with respect and are always willing to help. Location is good. Various shops and malls in walking distance. Very comfortable living.
Read More
Earl S.
Aug 3, 2023
Apartments are old and falling apart. The walls crumble to the touch, probably due to all of the mold. SEVERAL times I've come across maggots' crawling out of the baseboards!I've lived here 4 years, and it's the same thing every week; water shut offs, A/C is broken, maintenance needs to come into my apartments just to work on other apartments.The maintenance team is never any good. They all have excuses to why they can't fix anything..Had one tell me that the sun is the reason your a/c doesn't work right. And that I should keep all my windows covered..I have so many fans because of this a/c issue, as well as sun block out curtains always drawn..I wish I had something good to say...
Read More
Seth F.
Feb 28, 2022
I am a reasonable person that rarely leaves reviews. This place was HANDS DOWN the worst apartment living experience of my life. Not even going to waste my time writing out the infinite list of atrocities or stress that Four Winds introduced into my life the 9 months I lived here. Tenants Beware. And if you need more proof, sort by the newest comments and do your own research before signing. It's all true. Don't make the same mistake that I as well as so many other unfortunate tenants have. Also not sure why it is saying California. I live in Corpus Christi, Texas.
Read More
Reggie Y.
Mar 7, 2022
It is so gross here. The dumpsters aren't emptied enough so a mountain of garbage piles up by each dumpster. My move in ready apartment contained black mold that's as high as 3' on the walls, ceiling damage, wall damage, German cockroaches, missing smoke alarms, interior doors that don't close in case of fire, no porch light, missing window locks, dry rotted support beam for the deck over mine. I havent even been here 2 weeks and the water has been shut off 3 times. I know people wish they could leave a zero but on here a 1 star is a zero.
Read More
Noob S.
Jun 4, 2018
Hello , here is my honest review after living at the Four Winds Apartments for 2 yrs. Yea the staff was nice but nothing special. Then you sing the lease, for get it abandon all hope for empathy , forgiveness , and humanity . You are just a number . First day of move in they swore and said up down that the apartment after two long weeks was finally move in ready .The 1st night was discusting Roaches every where I spent my first night keeping them off my bed , the next morning I called them to fix the roach problem! They said we're sorry we can't do anything about it . the exterminator comes next month , you should go out get some raid and roach killing traps .. I knew this was a mistake . The manager brushed me off her shoulder and that was that .. 2nd make sure to make no mistake when paying your rent to this rats that run this roach cartel here at Four Winds Apartments . One mistake can cost you 50$ dollars and no sypothetic comprehension on there side even if its because their faulty paying system . Its better to pay with cashiers check than to use they're web site paying system " trust me on this one, it will save you money and sleepless nights " . That's if you make the mistake of leaving here . I know I truely made a mistake moving here . . 3rd pools are lame very nasty water , pool chairs are not maintained they are all broken . The maintains team around here look like they hate their life . Seriously after the first month of living here some of my kitchen things started falling apart like cabinets and lights not turning on etc. Made my request and no one ever came to help still making request . Seriously the maintains staff only gets paid to ride there little carts around the apartment complex and get in the way when your pulling out to leave . The front staff will get to know you very well because of your constant complaining and you will most likely be the elephant in there office , its just poorly managed no one wants to go out of there way to help .. The pay to work here must be Shit cause they hate every one that moves in ..
Read More






